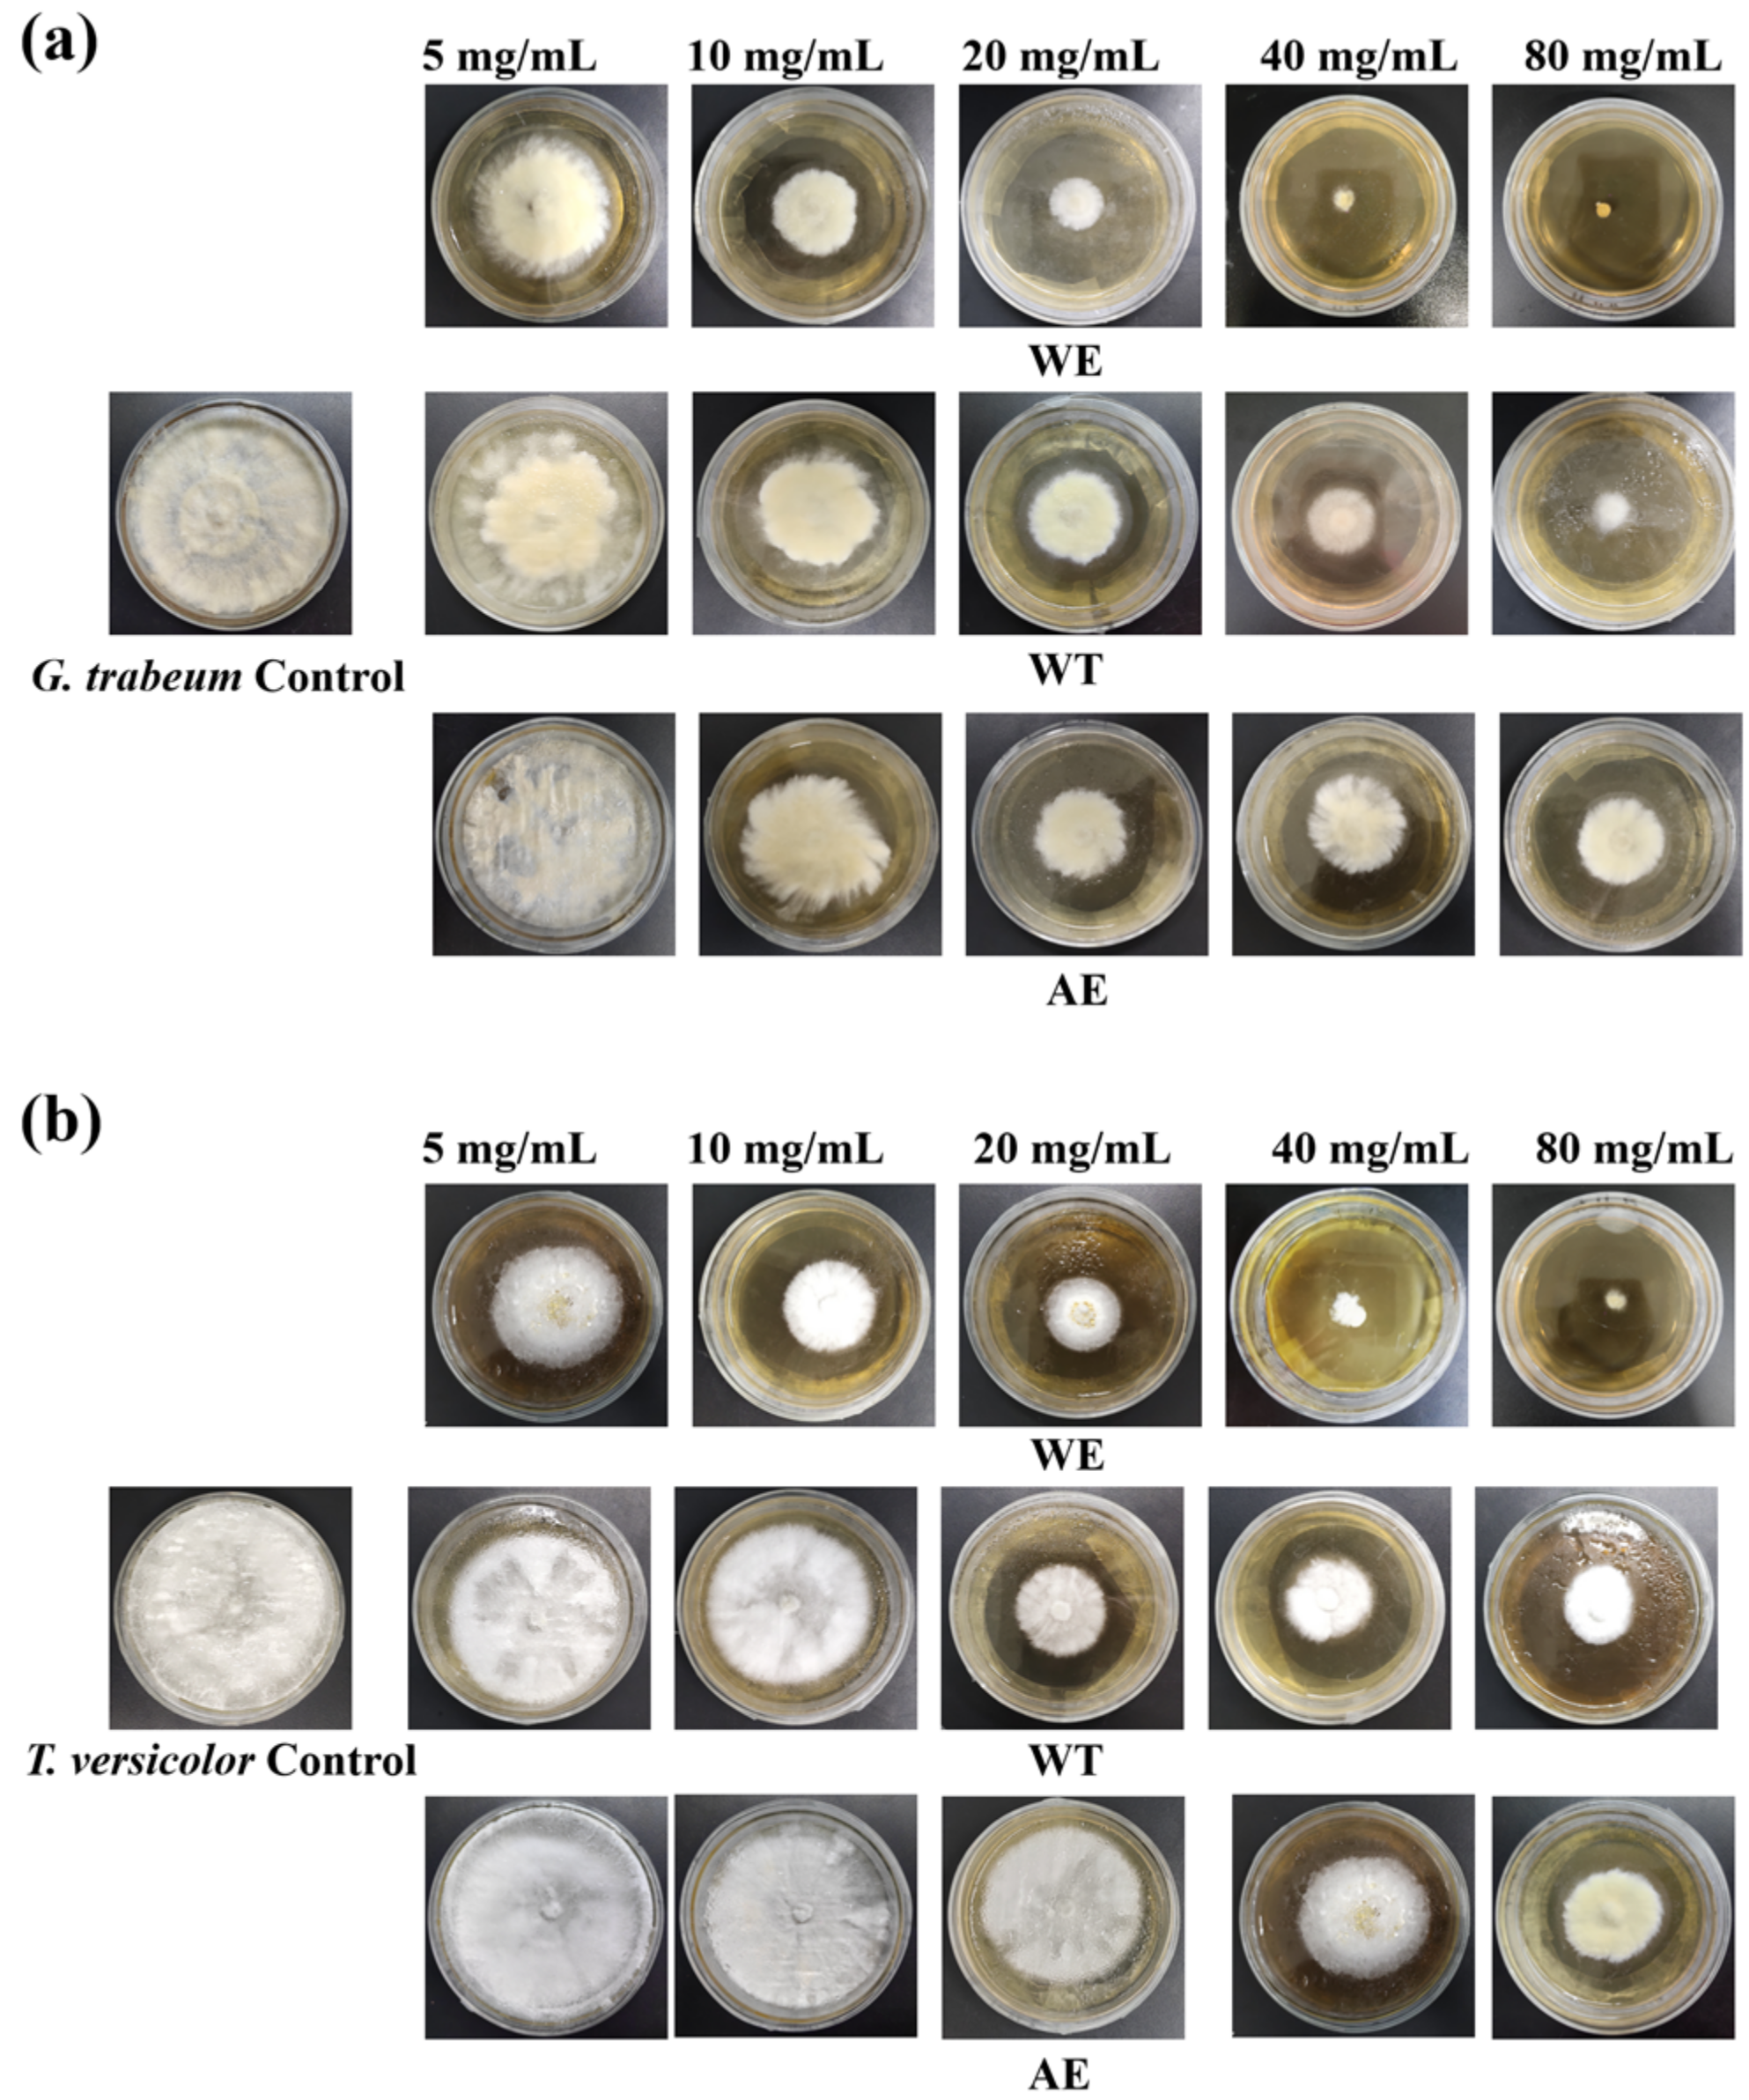
Forests 15 01274 g003

Evaluation of the Potentials of Tobacco Waste Extract as Wood Preservatives against Wood Decay Fungi
Abstract
1. Introduction
2. Materials and Methods
2.1. Materials
2.2. Extraction of Tobacco Wastes
2.3. Chemical Composition Analysis of Tobacco Waste Extracts via GC-MS
2.4. Antifungal Activity Test against Wood Decay Fungi
2.5. Antifungal Activity Test against Wood Decay Fungi
2.6. Wood Decay Resistance Tests
2.7. Acute Ecotoxicity Assessment
2.8. Statistical Analysis
3. Results and Discussion
3.1. Chemical Composition of Tobacco Waste Extracts
3.2. Antifungal Activity of Tobacco Waste Extracts against Wood Decay Fungi
3.3. Antifungal Activity of Major Constituents against Wood Decay Fungi
3.4. Retention Analysis
3.5. Wood Decay Resistance of Tobacco Waste Extracts
3.6. Acute Ecotoxicity Test
4. Conclusions
Author Contributions
Funding
Data Availability Statement
Acknowledgments
Conflicts of Interest
References
- Repič, R.; Pondelak, A.; Kržišnik, D.; Humar, M.; Škapin, A.S. Combining mineralisation and thermal modification to improve the fungal durability of selected wood species. J. Clean. Prod. 2022, 351, 131530. [Google Scholar] [CrossRef]
- Andeme Ela, R.C.; Chipkar, S.H.; Bal, T.L.; Xie, X.; Ong, R.G. Lignin–Propiconazole Nanocapsules are an Effective Bio-Based Wood Preservative. ACS Sustain. Chem. Eng. 2021, 9, 2684–2692. [Google Scholar] [CrossRef]
- Vek, V.; Balzano, A.; Poljanšek, I.; Humar, M.; Oven, P. Improving Fungal Decay Resistance of Less Durable Sapwood by Impregnation with Scots Pine Knotwood and Black Locust Heartwood Hydrophilic Extractives with Antifungal or Antioxidant Properties. Forests 2020, 11, 1024. [Google Scholar] [CrossRef]
- Marin Villegas, C.A.; Zagury, G.J. Incorporating oral, inhalation and dermal bioaccessibility into human health risk characterization following exposure to Chromated Copper Arsenate (CCA)-contaminated soils. Ecotoxicol. Environ. Saf. 2023, 249, 114446. [Google Scholar] [CrossRef] [PubMed]
- Kartal, S.N.; Terzi, E.; Yılmaz, H.; Goodell, B. Bioremediation and decay of wood treated with ACQ, micronized ACQ, nano-CuO and CCA wood preservatives. Int. Biodeterior. Biodegrad. 2015, 99, 95–101. [Google Scholar] [CrossRef]
- Mohajerani, A.; Vajna, J.; Ellcock, R. Chromated copper arsenate timber: A review of products, leachate studies and recycling. J. Clean. Prod. 2018, 179, 292–307. [Google Scholar] [CrossRef]
- Peng, Y.; Wang, Y.; Zhang, R.; Wang, W.; Cao, J. Improvement of wood against UV weathering and decay by using plant origin substances: Tannin acid and tung oil. Ind. Crop. Prod. 2021, 168, 113606. [Google Scholar] [CrossRef]
- Sommerauer, L.; Thevenon, M.-F.; Petutschnigg, A.; Tondi, G. Effect of hardening parameters of wood preservatives based on tannin copolymers. Holzforschung 2019, 73, 457–467. [Google Scholar] [CrossRef]
- Brocco, V.F.; Paes, J.B.; da Costa, L.G.; Brazolin, S.; Arantes, M.D.C. Potential of teak heartwood extracts as a natural wood preservative. J. Clean. Prod. 2017, 142, 2093–2099. [Google Scholar] [CrossRef]
- Bi, Z.; Morrell, J.J.; Lei, Y.; Yan, L.; Ji, M. Eco-friendly and mildly modification of wood cell walls with heat treated wood extracts to improve wood decay resistance. Ind. Crop. Prod. 2022, 184, 115079. [Google Scholar] [CrossRef]
- Tascioglu, C.; Yalcin, M.; Sen, S.; Akcay, C. Antifungal properties of some plant extracts used as wood preservatives. Int. Biodeterior. Biodegrad. 2013, 85, 23–28. [Google Scholar] [CrossRef]
- Woźniak, M.; Kwaśniewska-Sip, P.; Waśkiewicz, A.; Cofta, G.; Ratajczak, I. The Possibility of Propolis Extract Application in Wood Protection. Forests 2020, 11, 465. [Google Scholar] [CrossRef]
- Akçay, C.; Birinci, E.; Birinci, C.; Kolaylı, S. Durability of wood treated with propolis. BioResources 2020, 15, 1547–1562. [Google Scholar] [CrossRef]
- Xie, Y.; Wang, Z.; Huang, Q.; Zhang, D. Antifungal activity of several essential oils and major components against wood-rot fungi. Ind. Crop. Prod. 2017, 108, 278–285. [Google Scholar] [CrossRef]
- Barbero-López, A.; Chibily, S.; Tomppo, L.; Salami, A.; Ancin-Murguzur, F.J.; Venäläinen, M.; Lappalainen, R.; Haapala, A. Pyrolysis distillates from tree bark and fibre hemp inhibit the growth of wood-decaying fungi. Ind. Crop. Prod. 2019, 129, 604–610. [Google Scholar] [CrossRef]
- Barbero-López, A.; Monzó-Beltrán, J.; Virjamo, V.; Akkanen, J.; Haapala, A. Revalorization of coffee silverskin as a potential feedstock for antifungal chemicals in wood preservation. Int. Biodeterior. Biodegrad. 2020, 152, 105011. [Google Scholar] [CrossRef]
- Bi, Z.; Yang, F.; Lei, Y.; Morrell, J.J.; Yan, L. Identification of antifungal compounds in konjac flying powder and assessment against wood decay fungi. Ind. Crop. Prod. 2019, 140, 111650. [Google Scholar] [CrossRef]
- Shiny, K.S.; Remadevi, O.K.; Nagaveni, H.C.; Vijayalakshmi, G. Preliminary study on antifungal effect of coconut shell pyrolytic oil against wood decay fungi. Int. Wood Prod. J. 2013, 5, 124–126. [Google Scholar] [CrossRef]
- Jing, Y.; Gao, Y.; Wang, W.; Cheng, Y.; Lu, P.; Ma, C.; Zhang, Y. Optimization of the extraction of polysaccharides from tobacco waste and their biological activities. Int. J. Biol. Macromol. 2016, 91, 188–197. [Google Scholar] [CrossRef] [PubMed]
- Zou, X.; Bk, A.; Rauf, A.; Saeed, M.; Al-Awthan, Y.S.; AAl-Duais, M.; Bahattab, O.; Hamayoon Khan, M.; Suleria, H.A. Screening of Polyphenols in Tobacco (Nicotiana tabacum) and Determination of Their Antioxidant Activity in Different Tobacco Varieties. ACS Omega 2021, 6, 25361–25371. [Google Scholar] [CrossRef] [PubMed]
- Zou, X.; Bk, A.; Abu-Izneid, T.; Aziz, A.; Devnath, P.; Rauf, A.; Mitra, S.; Emran, T.B.; Mujawah, A.A.H.; Lorenzo, J.M.; et al. Current advances of functional phytochemicals in Nicotiana plant and related potential value of tobacco processing waste: A review. Biomed. Pharmacother. 2021, 143, 112191. [Google Scholar] [CrossRef] [PubMed]
- Yang, Y.-L.; Song, B.-Q.; Long, J.-Y.; Fang, D.-H.; Hu, D.-B.; Song, N.; Luo, J.-F.; Zeng, J.-M.; Wang, Y.-H. Antifungal constituents from Nicotiana tabacum with the Wz locus infected by Phytophthora nicotianae. Results Chem. 2021, 3, 100196. [Google Scholar] [CrossRef]
- Fernanda, S.A.; Amru, B.A.; Rahmani, H.A.; Gozan, M.; Irsyad, N.S.; Bahar, M.; Puspita, O.S.; Zulfa, F.; Pramono, A. Antibacterial Potential of Nicotiana tabacum L. var Virginia Pyrolysis Extract against Staphylococcus aureus, Enterococcus faecalis, Escherichia coli, and Pseudomonas aeruginosa. IOP Conf. Ser. Earth Environ. Sci. 2021, 755, 012013. [Google Scholar] [CrossRef]
- Khan, M.H.; Rauf, A.; Saeed, M.; Alomar, T.S.; Khalil, A.A.; AlMasoud, N.; Sharma, R.; Ribaudo, G. Computational and experimental investigation of antibacterial and antifungal properties of Nicotiana tabacum extracts. Open Chem. 2023, 21, 20220343. [Google Scholar] [CrossRef]
- Yıldız, Ü.C.; Yıldız, S.; Yılmaz, A.; Durmaz, S. Fungicidal effect of tobacco stalks (Nicotiana tabacum L.) against brown rot fungi “Coniophora puteana”. In Proceedings of the 47th Annual Meeting of the International Research Group in Wood Protection (IRG/WP 16-10865), Lisbon, Portugal, 15–19 May 2016. [Google Scholar]
- GB/T 13942.1-2009; DurabiIity of Wood—Part 1: Method for Laboratory Test of Natural Decay Resistance. Standard Press: Beijing, China, 2009.
- Banožić, M.; Aladić, K.; Jerković, I.; Jokić, S. Volatile organic compounds of tobacco leaves versus waste (scrap, dust, and midrib): Extraction and optimization. J. Sci. Food Agric. 2020, 101, 1822–1832. [Google Scholar] [CrossRef] [PubMed]
- Jokić, S.; Gagić, T.; Knez, Ž.; Banožić, M.; Škerget, M. Separation of active compounds from tobacco waste using subcritical water extraction. J. Supercrit. Fluids 2019, 153, 104593. [Google Scholar] [CrossRef]
- Biva, I.J.; Ndi, C.P.; Semple, S.J.; Griesser, H.J. Antibacterial Performance of Terpenoids from the Australian Plant Eremophila lucida. Antibiotics 2019, 8, 63. [Google Scholar] [CrossRef] [PubMed]
- Casciaro, B.; Calcaterra, A.; Cappiello, F.; Mori, M.; Loffredo, M.; Ghirga, F.; Mangoni, M.; Botta, B.; Quaglio, D. Nigritanine as a New Potential Antimicrobial Alkaloid for the Treatment of Staphylococcus aureus-Induced Infections. Toxins 2019, 11, 511. [Google Scholar] [CrossRef] [PubMed]
- Gonzalez-Rivera, M.L.; Barragan-Galvez, J.C.; Gasca-Martínez, D.; Hidalgo-Figueroa, S.; Isiordia-Espinoza, M.; Alonso-Castro, A.J. In Vivo Neuropharmacological Effects of Neophytadiene. Molecules 2023, 28, 3457. [Google Scholar] [CrossRef] [PubMed]
- El-Hefny, M.; Salem, M.Z.M.; Behiry, S.I.; Ali, H.M. The Potential Antibacterial and Antifungal Activities of Wood Treated with Withania somnifera Fruit Extract, and the Phenolic, Caffeine, and Flavonoid Composition of the Extract According to HPLC. Processes 2020, 8, 113. [Google Scholar] [CrossRef]
- Woźniak, M.; Kwaśniewska-Sip, P.; Krueger, M.; Roszyk, E.; Ratajczak, I. Chemical, Biological and Mechanical Characterization of Wood Treated with Propolis Extract and Silicon Compounds. Forests 2020, 11, 907. [Google Scholar] [CrossRef]
- Šimůnková, K.; Reinprecht, L.; Nábělková, J.; Hýsek, Š.; Kindl, J.; Borůvka, V.; Lišková, T.; Šobotník, J.; Pánek, M. Caffeine—Perspective natural biocide for wood protection against decaying fungi and termites. J. Clean. Prod. 2021, 304, 127110. [Google Scholar] [CrossRef]
- Valette, N.; Perrot, T.; Sormani, R.; Gelhaye, E.; Morel-Rouhier, M. Antifungal activities of wood extractives. Fungal Biol. Rev. 2017, 31, 113–123. [Google Scholar] [CrossRef]
- Aspera-Werz, R.H.; Ehnert, S.; Heid, D.; Zhu, S.; Chen, T.; Braun, B.; Sreekumar, V.; Arnscheidt, C.; Nussler, A.K. Nicotine and Cotinine Inhibit Catalase and Glutathione Reductase Activity Contributing to the Impaired Osteogenesis of SCP-1 Cells Exposed to Cigarette Smoke. Oxidative Med. Cell. Longev. 2018, 6, 1–13. [Google Scholar] [CrossRef]
- Wei, L.; Mi, S.; Wei, L.; Pu, D.; Zhu, M.; Lu, Q.; Chen, C.; Zu, Y. Integrated extraction-purification and anti-inflammatory activity of berberine-rich extracts from Coptis chinensis Franch. Ind. Crop. Prod. 2023, 202, 117029. [Google Scholar] [CrossRef]
- Docheva, M.; Dagnon, S.; Statkova-Abeghe, S. Flavonoid content and radical scavenging potential of extracts prepared from tobacco cultivars and waste. Nat. Prod. Res. 2014, 28, 1328–1334. [Google Scholar] [CrossRef] [PubMed]
- Boateng, I.D.; Kumar, R.; Daubert, C.R.; Flint-Garcia, S.; Mustapha, A.; Kuehnel, L.; Agliata, J.; Li, Q.; Wan, C.; Somavat, P. Sonoprocessing improves phenolics profile, antioxidant capacity, structure, and product qualities of purple corn pericarp extract. Ultrason. Sonochem. 2023, 95, 106418. [Google Scholar] [CrossRef] [PubMed]
- Li, Q.; Zhu, X.; Xie, Y.; Zhong, Y. o-Vanillin, a promising antifungal agent, inhibits Aspergillus flavus by disrupting the integrity of cell walls and cell membranes. Appl. Microbiol. Biotechnol. 2021, 105, 5147–5158. [Google Scholar] [CrossRef] [PubMed]
- Li, Q.; Zhu, X.; Xie, Y.; Ren, S. 2-Hydroxy-4-methoxybenzaldehyde inhibits the growth of Aspergillus flavus via damaging cell wall, cell membrane, manipulating respiration thus creating a promising antifungal effect on corn kernels. Int. J. Food Sci. Technol. 2020, 56, 178–184. [Google Scholar] [CrossRef]
- Sánchez-Fernández, R.E.; Sánchez-Fuentes, R.; Rangel-Sánchez, H.; Hernández-Ortega, S.; López-Cortés, J.G.; Macías-Rubalcava, M.L. Antifungal and antioomycete activities and modes of action of isobenzofuranones isolated from the endophytic fungus Hypoxylon anthochroum strain Gseg1. Pestic. Biochem. Physiol. 2020, 169, 104670. [Google Scholar] [CrossRef]

| Class of Resistance | Mass Loss of Softwood (%) | Mass Loss of Hardwood (%) |
|---|---|---|
| Highly resistant (I) | 0–10 | 0–10 |
| Resistant (II) | 11–20 | 11–30 |
| Moderately resistant (III) | 21–30 | 31–50 |
| Non-resistant (IV) | >30 | >50 |
| No. | Retention Time/min | Compound Name | Molecular Formula | Molecular Weight | Relative Content/% | ||
|---|---|---|---|---|---|---|---|
| WT | AE | WE | |||||
| 1 | 4.71 | 2-Methylbutyric Acid | C5H10O2 | 102.13 | 0.25 | 0.02 | 0.04 |
| 2 | 8.55 | Benzyl alcohol | C7H8O | 108.13 | 0.02 | 0.01 | 0.01 |
| 3 | 9.81 | 2,3,5,6-Tetramethylpyrazine | C8H12N2 | 136.19 | 0.03 | - | - |
| 4 | 10.13 | Linalool | C10H18O | 154.25 | 0.29 | - | - |
| 5 | 10.47 | Phenethyl alcohol | C8H10O | 122.17 | 0.02 | 0.01 | 0.01 |
| 6 | 11.91 | Dihydrolianalool | C10H20O | 156.27 | 0.06 | 0.01 | 0.01 |
| 7 | 12.02 | Octanoic acid | C8H16O2 | 144.21 | 0.06 | - | - |
| 8 | 12.26 | 4-isopropylcyclohex-2-en-1-one | C9H14O2 | 138.21 | 0.46 | - | - |
| 9 | 13.56 | Ethyl phenylacetate | C10H12O2 | 164.20 | 0.04 | - | - |
| 10 | 14.31 | 1-Cyclohexene-1-carboxaldehyde,4-(1-methylethenyl)- | C10H14O | 150.22 | 0.05 | - | - |
| 11 | 15.95 | Nicotine | C10H14N2 | 162.23 | 7.02 | 6.29 | 9.32 |
| 12 | 16.33 | Solanone | C13H22O | 194.31 | 1.82 | 0.25 | 0.26 |
| 13 | 16.76 | β-Damascone | C13H20O | 192.30 | 0.08 | - | - |
| 14 | 18.15 | 6,10-dimethylundeca-5,9-dien-2-one | C13H22O | 194.31 | 0.31 | 0.03 | 0.05 |
| 15 | 18.81 | 3-(1-Methyl-1H-pyrrol-2-yl) pyridine | C10H10N2 | 158.20 | - | 0.07 | 0.09 |
| 16 | 19.77 | 2,3′-Bipyridine | C10H8N2 | 156.18 | 0.18 | 0.08 | 0.11 |
| 17 | 19.84 | Dihydroactinidiolide | C11H16O2 | 180.24 | 0.19 | 0.06 | 0.07 |
| 18 | 20.42 | Tabanone A | C13H18O | 190.28 | 0.25 | 0.03 | 0.04 |
| 19 | 20.77 | Tabanone B | C13H18O | 190.28 | 1.37 | 0.17 | 0.19 |
| 20 | 21.43 | Tabanone C | C13H18O | 190.28 | 0.28 | ----- | ----- |
| 21 | 21.67 | Tabanone D | C13H18O | 190.28 | 0.94 | 0.13 | 0.16 |
| 22 | 23.07 | 4-(3-Hydroxybutyl)-3,5,5-trimethyl-2-cyclohexen-1-one | C13H22O2 | 210.31 | 0.34 | 0.13 | 0.16 |
| 23 | 24.21 | Benzyl benzoate | C14H12O2 | 212.24 | 0.2 | - | - |
| 24 | 24.62 | Tetradecanoic acid ethyl ester | C16H32O2 | 256.42 | 0.26 | - | - |
| 25 | 25.45 | Neophytadiene | C20H38 | 278.52 | 10.07 | 8.82 | 8.78 |
| 26 | 25.52 | Phytone | C18H36O | 268.48 | 0.37 | 0.2 | 0.21 |
| 27 | 26.77 | 2,6,10-Trimethyl-2,6,10-pentadecatrien-14-one | C18H30O | 262.43 | 0.65 | 0.38 | 0.48 |
| 28 | 26.85 | Methyl palmitate | C17H34O2 | 270.45 | 0.71 | 0.38 | 0.33 |
| 29 | 27.12 | Cembrene | C20H32 | 272.46 | 0.21 | 0.24 | - |
| 30 | 27.95 | Hexadecanoic acid ethyl ester | C18H36O2 | 284.48 | 1.08 | - | 0.49 |
| 31 | 29.63 | Methyl linolenate | C19H32O2 | 292.46 | 2.43 | - | - |
| 32 | 29.85 | Phytol | C20H40O | 296.53 | 1.91 | - | - |
| 33 | 30.54 | Ethyl linoleate | C20H36O2 | 308.50 | 1.46 | - | - |
| 34 | 31.84 | 2,7,11-Cembratriene-4,6-Diol | C20H34O2 | 306.00 | 5.15 | 8.78 | 13.61 |
| 35 | 43.48 | Cholesterol | C27H46O | 386.65 | - | 0.05 | 0.07 |
| 36 | 45.65 | Campesterol | C28H48O | 400.69 | - | 0.03 | 0.08 |
| 37 | 46.38 | Stigmasterol | C29H48O | 412.69 | - | 0.1 | 0.16 |
| 38 | 47.77 | γ-Sitosterol | C29H50O | 414.70 | - | 0.03 | 0.04 |
| Extractive | Concentration (mg/mL) | Retention of Pinus yunnanensis (kg/m3) | Retention of Hevea brasiliensis (kg/m3) |
|---|---|---|---|
| Water extractive | 5 | 2.88 ± 0.10 | 2.65 ± 0.25 |
| 10 | 3.73 ± 0.42 | 4.16 ± 0.31 | |
| 20 | 8.56 ± 0.31 | 9.59 ± 0.74 | |
| 40 | 17.11 ± 0.49 | 18.56 ± 0.57 | |
| 80 | 33.46 ± 0.64 | 36.75 ± 0.33 | |
| 50% ethanol extractive | 5 | 2.06 ± 0.15 | 2.95 ± 0.23 |
| 10 | 4.75 ± 0.23 | 5.98 ± 0.39 | |
| 20 | 9.82 ± 0.50 | 11.71 ± 0.74 | |
| 40 | 18.69 ± 0.46 | 20.77 ± 0.55 | |
| 80 | 31.90 ± 0.71 | 35.68 ± 0.64 | |
| Absolute ethanol extractive | 5 | 2.98 ± 0.26 | 3.09 ± 0.17 |
| 10 | 5.83 ± 0.36 | 6.06 ± 0.49 | |
| 20 | 11.68 ± 0.74 | 12.23 ± 0.82 | |
| 40 | 17.84 ± 0.29 | 19.55 ± 0.57 | |
| 80 | 30.24 ± 0.56 | 33.88 ± 0.70 |
Disclaimer/Publisher’s Note: The statements, opinions and data contained in all publications are solely those of the individual author(s) and contributor(s) and not of MDPI and/or the editor(s). MDPI and/or the editor(s) disclaim responsibility for any injury to people or property resulting from any ideas, methods, instructions or products referred to in the content. |
© 2024 by the authors. Licensee MDPI, Basel, Switzerland. This article is an open access article distributed under the terms and conditions of the Creative Commons Attribution (CC BY) license (https://creativecommons.org/licenses/by/4.0/).
Share and Cite
Liu, L.; Tian, J.; Zhou, Z.; Yang, C.; Yang, S.; Zhang, K.; Yang, Y.; Qiu, J. Evaluation of the Potentials of Tobacco Waste Extract as Wood Preservatives against Wood Decay Fungi. Forests 2024, 15, 1274. https://doi.org/10.3390/f15071274
Liu L, Tian J, Zhou Z, Yang C, Yang S, Zhang K, Yang Y, Qiu J. Evaluation of the Potentials of Tobacco Waste Extract as Wood Preservatives against Wood Decay Fungi. Forests. 2024; 15(7):1274. https://doi.org/10.3390/f15071274
Chicago/Turabian StyleLiu, Lin, Junkai Tian, Ziyao Zhou, Chunwang Yang, Susu Yang, Kangkang Zhang, Yushan Yang, and Jian Qiu. 2024. "Evaluation of the Potentials of Tobacco Waste Extract as Wood Preservatives against Wood Decay Fungi" Forests 15, no. 7: 1274. https://doi.org/10.3390/f15071274
APA StyleLiu, L., Tian, J., Zhou, Z., Yang, C., Yang, S., Zhang, K., Yang, Y., & Qiu, J. (2024). Evaluation of the Potentials of Tobacco Waste Extract as Wood Preservatives against Wood Decay Fungi. Forests, 15(7), 1274. https://doi.org/10.3390/f15071274





